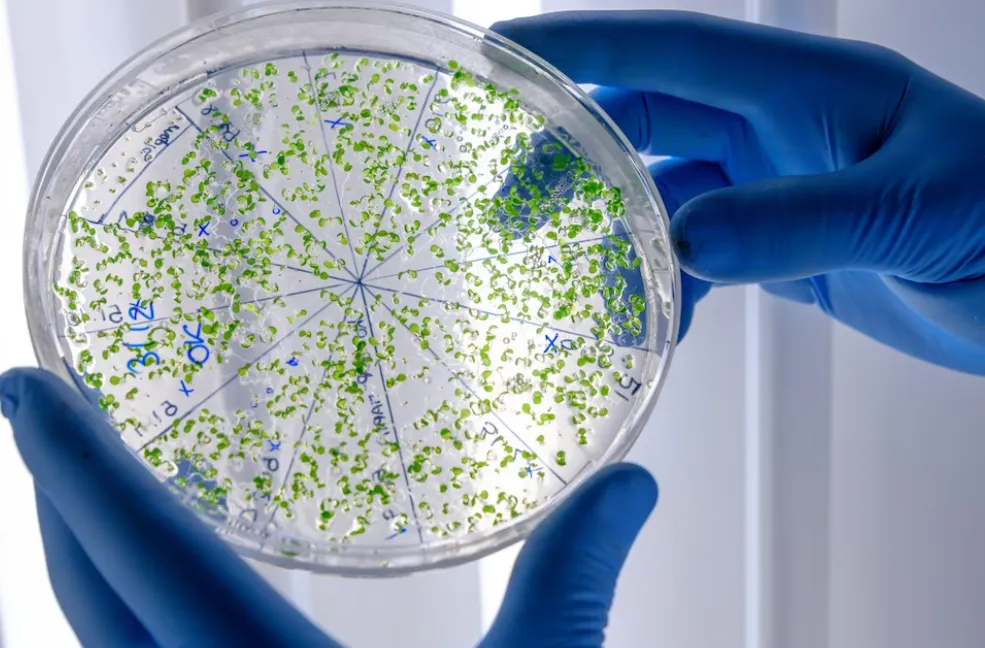
اهداف واهمية دراسة تخصص مختبر علم الامراض في تركيا
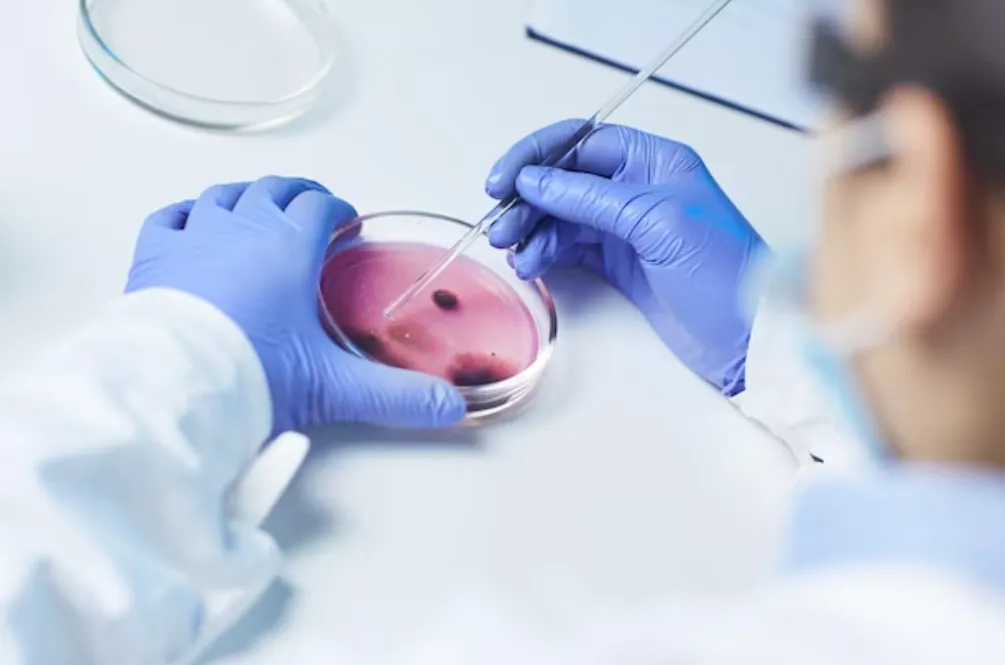
الوظائف المتاحة لخريجي تخصص مختبر علم الامراض في تركيا

مقدمة
هذا المقال بقلم: د. مازن صافي
ان الغرض من دراسة مختبر علم الامراض، هو تدريب الطلاب ليتمكنوا من إجراء التحليلات الطبية التي تكمن أهميتها في التشخيص ومعرفة الامراض والتمييز بينها. ويمتلك خريجو التخصص في تركيا القدرات الكافية لإجراء التحليلات المخبرية كافة.
تستقطب تركيا الطلاب الأجانب لدراسة التخصص فيها، لما تتميز به الجامعات من سمعة علمية مرموقة وترتيب متقدم بين الجامعات العالمية، وكما زادت الحاجة الى الفنيين، وأصبحوا جزء لا يتجزأ من المنظومة الطبية وصنع القرار الطبي.
يمكن لفنيي مختبر علم الأمراض العثور على فرص عمل في مختبر علم الأمراض في الجامعات والمستشفيات العامة والخاصة ومختبر علم الأمراض الخاصة ومختبر الأنسجة في كليات الطب ومختبر علم الأمراض الجزيئية ومختبر الطب الشرعي.
ما هو تخصص مختبر علم الامراض في تركيا
تخصص مختبر علم الامراض يبنى على التقنيات المخبرية وعمليات فحص وتقييم الانسجة وسوائل الجسم المختلفة.
يتم تزويد المختبر والمراكز البحثية بأحدث الأجهزة الخاصة بجودة عمليات الفحص واجراء عمليات أكثر تطورا وتلبية طلبات الأطباء في التمييز المخبرية بين مسببات الامراض.
يهدف برنامج تقنيات علم الأمراض إلى فهم وتطبيق التقنيات الكيميائية النسيجية والكيميائية المناعية والخلوية الروتينية المستخدمة في مختبر علم الأمراض من خلال تعلم عملية تحضير الأنسجة البشرية أو الحيوانية للفحص المرضي في مختبرات علم الأمراض.
أهداف واهمية دراسة تخصص مختبر علم الامراض في تركيا
تزداد الحاجة الى الخريجين من تخصص مختبر الأمراض، طرديا مع زيادة عدد الأطباء المتخصصين وزيادة أنواع الأمراض وانتشارها في العالم.
امتلاك الطلاب المعرفة والمهارات العلمية، بجانب الممارسة والتدريب العملي؛ للتمكن من إجراء التحليلات الكيميائية الحيوية والأحياء الدقيقة، والمرضية وفحص الدم للمواد الطبية باستخدام معدات المختبر والآلات والأدوات الخاصة.
القدرة على تنفيذ جميع الخدمات الفنية وتطبيق التكنولوجيا اللازمة حتى تصبح الأنسجة وسوائل الجسم جاهزة للفحص المجهري.
القدرة على فحص الانسجة بواسطة المجهر، والتمييز بين الخلايا الطبيعية وغير الطبيعية، والإبلاغ عن نتائج الاختبار، وتطهير المعدات المختبرية.
يحتل التشخيص المرضي مكانة مهمة في تشخيص الأمراض. يحتل فنيو مختبر علم الأمراض الذين يمتلكون المعدات التقنية والنظرية الكاملة مكانًا مهمًا في هذا المجال حيث يتم استخدام التكنولوجيا المتقدمة والتقنيات الجديدة.
المسمى الفني لخريجي مختبر علم الامراض في تركيا
ان المتخصصين في مختبر علم الأمراض اهم فنيو واخصائيو الصحة المسؤولين عن كافة الإجراءات التي تؤدي الى سلامة التشخيص الطبي وما يتبعه من وصف الأدوية، ومن مسمياتهم الفنية والإدارية:
فني علم الأمراض
أخصائي مختبر (مخبري)
هذه هي الالقاب التي تُمنح للشخص الذي يقوم بإجراء فحوصات مجهرية لسوائل وأنسجة الجسم التي يتم إرسالها إلى المختبر من قبل الأطباء المختصين والذي يعمل على عينات المواد القادمة إلى مختبر علم الأمراض.
اقرأ أيضًا: دراسة علم الاحياء الجزيئي في تركيا
مميزات دراسة تخصص مختبر علم الامراض في تركيا
توفر كلية مختبر علم الامراض في الجامعات التركية المراكز البحثية والمعامل والمختبر العملية والمنهاج النظري وفق المعايير العالمية وذلك لإكساب الطلاب المهارات العملية وتطبيقات مهنة المختبرات.
تعزيز جوانب أخلاقيات المهنة لدى الطلاب بالإضافة إلى التفكير المنطقي وتعلم مهارات اتخاذ القرار وفق مختبر علم الأمراض ومعالجتها.
تعمل الجامعات التركية على تزويد الطلاب بأحدث المعلومات في مختبر علم الامراض، لغرض مواكبة التطور التكنولوجي والمتعلق بالوظائف المخبرية وكما تساهم في رفع مستوى الجوانب النظرية ودمج الممارسة المهنية لدى الطلاب.
تتميز دراسة مختبر علم الامراض في الجامعات التركية بتوفير تدريب عملي يعد من أفضل وأقوى أنواع التدريب والممارسة، وتتميز المستشفيات التي يتدرب فيها الطلاب بالإمكانيات من حيث الموارد البشرية واللوجستية ووفق المعايير العالمية.
تكاليف الدراسة في تخصص مختبر علم الامراض في تركيا تعتبر منخفضة عند مقارنتها بالجامعات الأوروبية او الامريكية.
يمكن للطلاب اختيار لغة الدراسة، ويعتبر هذا عامل جذب كبير للطلاب الدوليين، فالجامعات التركية لا تشترط الدراسة باللغة التركية في جامعاتها.
تقدم الجامعات التركية لطلابها مناهج تعليمية اكاديمية وعملية متطور، تواكب فيها أحدث ما توصلت اليها البحوث العلمية على مستوى العالم في مجال مختبر علم الامراض.
تتميز شهادة مختبر علم الامراض من تركيا، بانها قوية ومعترف بها ويتمكن الخريج من العمل بها في دول العالم.
يمكن لأخصائي مختبر علم الامراض في تركيا العمل في مجالات تخصصية ووظيفية وطبية مختلفة.
تعتبر دراسة تخصص مختبر علم الأمراض من أكثر الرغبات التي يحددها الطلاب الأجانب في اختيار التخصصات التركية.
تخصص مختبر علم الأمراض، يعتبر من التخصصات والمجالات الطبية التي يمكن النجاح فيها وتقدم للخريجين إمكانيات الدخول السريع في سوق العمل وبمكانة مجتمعية لائقة.
تعمل الجامعات التركية على تخرج طلاب مؤهلين من الناحية الأكاديمية النظرية العلمية والناحية العملية والممارسة التطبيقية.
تعمل الجامعات التركية من خلال معامل التخصص والتدريب الميداني في المراكز الطبية والمستشفيات على تزويد الطلاب والخريجين بالقدرات الفنية على التعامل مع التقنيات والأجهزة المخبرية الحديثة ومواكبة الأجهزة المرتبطة بالتكنولوجيا.
تعمل الجامعات التركية على تحفيز طلابها في تخصص مختبر علم الأمراض على تعزيز المهارات والمعرفة في مجال البحث العلمي والأوراق العملية.
اقرأ أيضًا: مميزات دراسة معهد مختبرات طبية في تركيا
أقسام تخصص مختبر علم الامراض في تركيا
التشخيص الجزئي والجينات
تخصص الأنسجة والخلايا المرضية
تخصص الأحياء الدقيقة الطبية
تخصص الكيمياء الحيوية
تخصص أمراض الدم ونقل الدم

السمات الشخصية ومهارات الطلاب في مختبر علم الامراض في تركيا
يتمتع الطالب بالحذر والدقة
القدرة العمل في بيئة فرق العمل الطبية المشتركة
التمتع بمستوى علمي مرتفع في علوم الاحياء والكيمياء
القدرة على العمل في الأماكن المنطقة.
التمتع بسمات التخطيط والممارسة الدقيقة
ان يكون الطالب سليم صحيا من أي أمراض لها علاقة بتمييز الألوان
مهارات التواصل والتفكير المنطقي والنقدي
يتمتع الطالب بالقدرة على استكشاف الأخطاء ودقة الملاحظة وحل المشكلات
يتمتع خريجو مختبر علم الامراض بمهارات العمل الجماعي القوية
يتمتع الطلاب بالقدرة على قضاء وقت طويل في التدريب
الطلاب لديهم خصائص القدرة على البحث العلمي والبحث عن مصادر المعلومات
المهارة الكتابية حيث إن مختصو المختبر لهم قدرات إبداعية في كتابة التقارير
مهارات استخدام الحاسوب والأجهزة الذكية والتقنية الأخرى
يكون لدى الطالب الشغف بالتحليل المخبري ومتفوق علميا
يمتلك الطالب مهارات الفهم والتفكير المنطقي والتحليلي
لدى الطالب مهارات إدارة الوقت وترتيب الأولويات.
المواد الدراسية لتخصص مختبر علم الامراض في تركيا
الأحياء
الاخلاقيات المهنية
الإدارة والخدمات الصحية
الإسعافات الأولية
البكتريا الطبية.
البيولوجيا الجزيئية
التحضيرات المجهرية
التخصصات المرتبطة بمختبر علم الامراض في تركيا
تدريب ميداني
تشريح مجهري
تطبيق تقنيات مختبر علم الأمراض
تقنيات التحاليل المخبرية
تقنيات علم الأمراض الجزيئية
تقنية الأنسجة العامة
التكنولوجيا الحيوية
تكنولوجيا الخلايا
الرياضيات الأساسية
سلامة المختبر
سوائل الجسم
الطب الشرعي
علم الاحياء الدقيقة السريري
علم الأحياء الدقيقة العام
علم الامراض
علم الأمراض الجزيئي
علم الانسجة
علم التشريح
علم الخلية
علم الطفيليات
علم الفيروسات
علم المناعة
علم الوراثة
علم وظائف الأعضاء
الكيمياء الحيوية
الكيمياء الحيوية السريرية
كيمياء عامة
مبادئ التمريض
مباديء بنك الدم.
مباديء صحة المرأة.
مباديء علم الأدوية.
مباديء علم الدم.
مباديء علم السموم.
مباديء علم الطفيليات.
المصطلحات الطبية
معلومات الأمراض
المفاهيم الأساسية في علم الأمراض
مقدمة في امراض الدم
مقدمة في علوم المختبر الطبية
مواد الأحياء الدقيقة في الأغذية.
الهندسة الوراثية
وظائف الأعضاء البشرية "الفسيولوجية"
اقرأ أيضًا: دراسة تخصص التحاليل الطبية في تركيا
الوظائف المتاحة لخريجي تخصص مختبر علم الامراض في تركيا
يتمتع خريجو تخصص مختبر علم الامراض في تركيا بالكثير من فرص العمل العامة والخاصة ومنها المجالات التالية:
مختبر الباثولوجي العامة
مختبر الباثولوجي الجزيئية
العمل في المستشفيات والمراكز الطبية الحكومية والخاصة
العمل في المجال التعليمي والبحثي والأكاديمي
يمكن للخريجين العمل في الكثير من المراكز الصحية والعيادات الخاصة
يمكن العمل في مراكز التحاليل والبحث العلمي
العمل في المجالات الاكاديمية والمعاهد الصحية
العمل في مؤسسات صناعة الأغذية
العمل في مؤسسات الرقابة والتحليل الغذائي والجودة
العمل في مختبر علم الأمراض (والخاصة منها).
العمل في مختبر الطب الشرعي
العمل في مختبر الأنسجة في كلية الطب
العمل في مختبر علم الأمراض الجزيئية في الجامعات
العمل في بنوك الدم
العمل في معامل ومصانع الأدوية
العمل في إدارة الجودة ومراقبة المنتجات
العمل في مصانع التغذية والمشروبات
الرسوم السنوية الدراسية في تخصص مختبر علم الأمراض في تركيا
أولا: إجمالي تكاليف دراسة مختبر علم الأمراض في الجامعات التركية
في الجامعات التركية الحكومية
تكاليف الدراسة لدراسة التخصص تتراوح ما بين 400 الى 1000 $ سنويا.
في الجامعات التركية الخاصة
تكاليف الدراسة لدراسة التخصص تتراوح ما بين 1100 الى 3300 $ سنويا، ويمكن متابعة الرسوم السنوية من خلال ما يلي:
الرسوم السنوية لدراسة مختبر علم الأمراض في تركيا
جامعة إسطنبول بيلجي: 2000 $
جامعة إسطنبول جيليشيم: 2750 $
جامعة إسطنبول ميديبول: 2800 $
جامعة اسكودار: 2500 $
جامعة أوكان: 2900 $
جامعة أيدن: 2700 $
جامعة بكينت: 1700 $
جامعة بيروني: 1750 $
جامعة فنار بهتشه: 1575 $
الرسوم السنوية لدراسة المختبرات الطبية في تركيا
جامعة أنقرة أتيليم: 4900 $
جامعة أستينيا: 3240 $
جامعة إسطنبول أطلس: 2000 $
جامعة إسطنبول توبكابي: 1450 $
جامعة إسطنبول جيليشيم: 2750 $
جامعة إسطنبول ميديبول: 2800 $
جامعة إسطنبول يني يوزيل: 1300 $
جامعة أسكودار: 2500 $
جامعة ألتن باش: 1500 $
جامعة انقرة ميديبول: 3000 $
جامعة أوكان: 2900 $
جامعة إسطنبول أيدن: 2700 $
جامعة اريل: 2000 $
جامعة بهتشه شهير: 3200 $
جامعة بيكينت: 1700 $
جامعة بيروني: 1750 $
جامعة فناربهتشه: 1575 $
جامعة كينيت: 1600 $
جامعة نيشان تاشي: 1600 $
عدد سنوات الدراسة في تخصص مختبر علم الامراض في تركيا
مدة الدراسة في مختبر علم الامراض، 4 سنوات بمعدل 8 فصول دراسية، والدراسة تكون باللغة التركية
تضاف سنة تحضيرية لتعلم اللغة في حال لم يقدم الطالب شهادة اجتياز للغة الإنجليزية.
اقرأ أيضًا: أفضل 3 تخصصات طبية يمكنك دراستها في تركيا
الأوراق المطلوبة للتسجيل في تخصص مختبر علم الامراض في تركيا
صورة شخصية بخلفية بيضاء
صورة جواز السفر "مترجم إلى الإنجليزية أو التركية"
شهادة الثانوية العامة النهائية "بيان الدرجات" وموثقة إذا كنت قد أنهيت الثانوية العامة.
شهادة آخر فصل دراسي إذا كان على وشك الإنهاء "مترجم إلى الإنجليزية أو التركية".
جميع الوثائق المقدمة يجب أن تكون معتمدة من الجهات الخاصة تعليمات واشتراطات التعليم العالي التركي للطلاب الدوليين.
لا تطلب الجامعات التركية الخاصة تقديم شهادة YOS أو SAT ويتم قبول الطالب الحاصل على نسبة 50 % في الثانوية العامة.
إذا ما زلت بحاجة إلى معرفة أي استفسار آخر فنحن هنا لمساعدتك، لذلك بإمكانك دائمًا التواصل:
عبر الاتصال:
0095437394024
أو الواتساب من خلال هذا الرابط.





